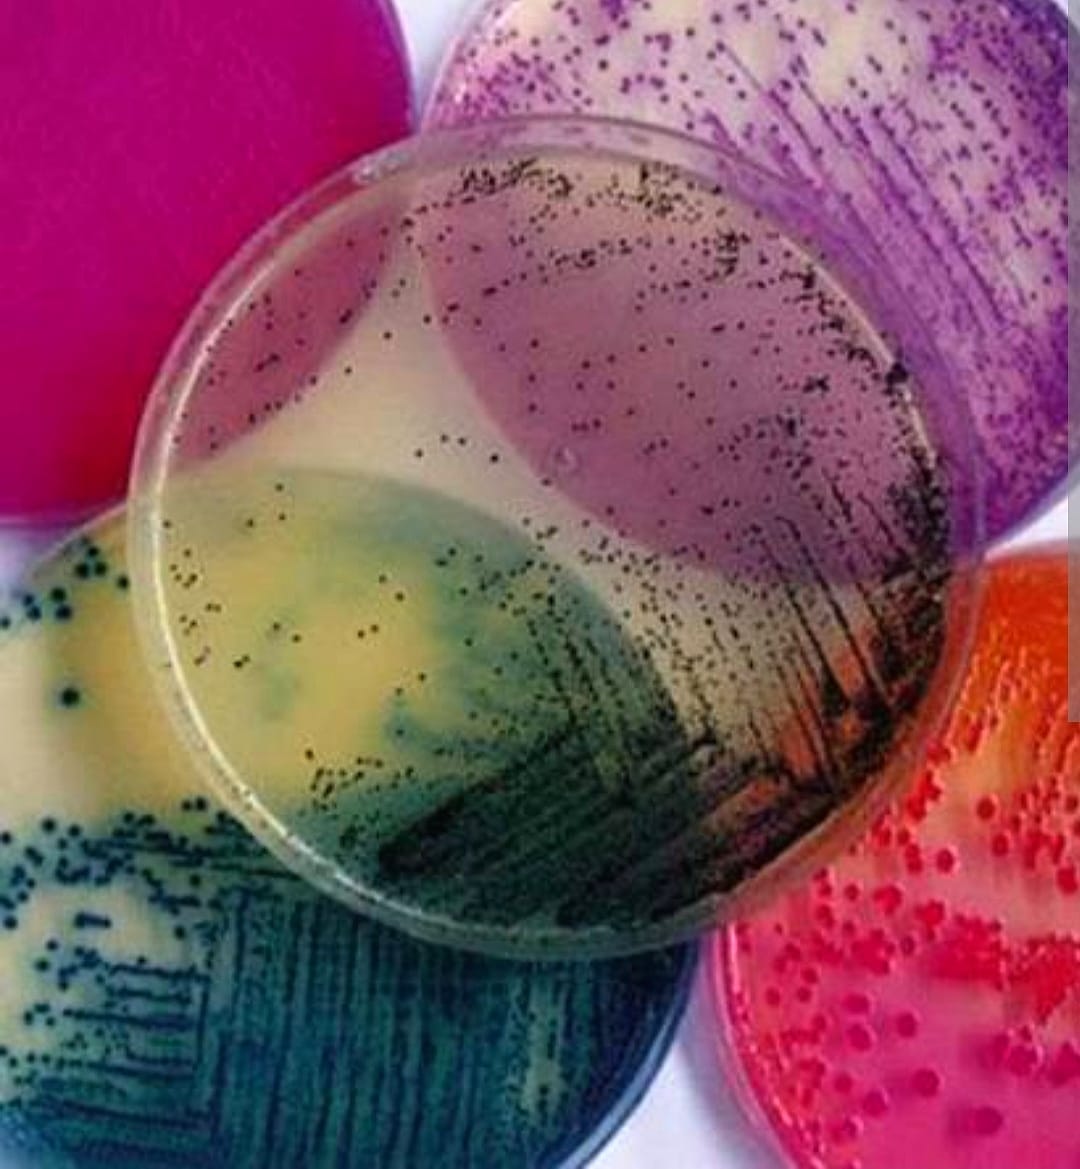

Leader du matériel
de laboratoire en
Tunisie
Nous accompagnons les laboratoires, cliniques et industries avec des équipements fiables.
Nos catégories de produits
Nos solutions de laboratoire
Marques leaders du laboratoire


















Trouvez votre matériel de laboratoire plus rapidement et au meilleur prix
Gagnez du temps dans vos recherches.
Accédez facilement aux références et fournisseurs adaptés à vos besoins grâce à notre plateforme.
Décrivez votre besoin
Remplissez simplement votre demande en quelques clics avec les critères
nécessaires.
nécessaires.
Nous transmettons votre
demande aux fournisseurs
Notre équipe contacte les vendeurs qualifiés pour vous proposer les meilleures offres.
Recevez vos devis rapidement
Recevez vos devis rapidement
Décrivez votre besoin
Remplissez simplement votre demande en quelques clics avec les critères
nécessaires.
nécessaires.
Nous transmettons votre
demande aux fournisseurs
Notre équipe contacte les vendeurs qualifiés pour vous proposer les meilleures offres.
Recevez vos devis rapidement
Recevez vos devis rapidement